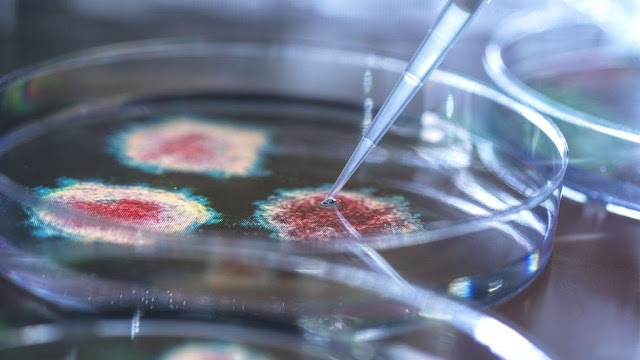

![]() |
| Do Germs Really Exist Despite Scientific Evidence? |
Do Germs Really Exist Despite Scientific Evidence?
Introduction
In a world filled with scientific advancements and microscopic discoveries, the existence of germs has become a topic of debate and intrigue. While science has undeniably proven the existence of these minuscule organisms, there are still individuals who question their reality. This article delves into the world of germs, exploring the scientific evidence that firmly establishes their existence, while addressing common misconceptions and doubts. Join us on this fascinating journey through the microbial world as we uncover the truth about germs.
The Microscopic Universe
Understanding Microorganisms
Before we dive into the question of germs' existence, let's begin by understanding what microorganisms are. Microorganisms, often referred to as microbes, are tiny living organisms that cannot be seen with the naked eye. They include bacteria, viruses, fungi, and protozoa.
The Discovery of Microbes
Microbes were first discovered in the late 17th century when Antonie van Leeuwenhoek used a rudimentary microscope to observe them. His pioneering work laid the foundation for microbiology, proving that a world of unseen life existed all around us.
The Germ Theory of Disease
Louis Pasteur's Breakthrough
One of the pivotal moments in the study of germs was Louis Pasteur's groundbreaking research in the 19th century. He proposed the Germ Theory of Disease, which asserted that many diseases are caused by microorganisms. Pasteur's work revolutionized medicine and led to the development of vaccines.
Modern Confirmation
Today, the Germ Theory of Disease is firmly established in scientific circles. Advances in technology have allowed us to directly observe germs and their role in causing illnesses.
Evidence of Germs
Microscopy
The most direct evidence of germs comes from microscopy. Powerful microscopes reveal the intricate structure of bacteria, viruses, and other microbes. Scientists have captured vivid images of these tiny organisms, leaving no room for doubt.
Germ Cultures
In laboratories worldwide, scientists cultivate and study various germs in controlled environments. These cultures provide a hands-on way to observe the behavior and characteristics of different microorganisms.
Disease Transmission
The transmission of diseases through germs is a well-documented phenomenon. From the common cold to more severe infections like COVID-19, the spread of diseases can often be traced back to the presence of germs.
Addressing Doubts
Conspiracy Theories
Despite overwhelming evidence, there are conspiracy theories that claim germs are a hoax. Such theories often lack scientific basis and rely on misinformation.
Misinterpretation
Sometimes, misinterpretation of scientific concepts can lead to doubts about germs' existence. It's essential to rely on credible sources for accurate information.
Conclusion
In conclusion, the existence of germs is unequivocally supported by scientific evidence. From the pioneering work of Antonie van Leeuwenhoek to modern advancements in microbiology, our understanding of germs has grown exponentially. While doubts and conspiracy theories persist, they should not overshadow the wealth of knowledge we have accumulated about these microscopic organisms.

0 Comments